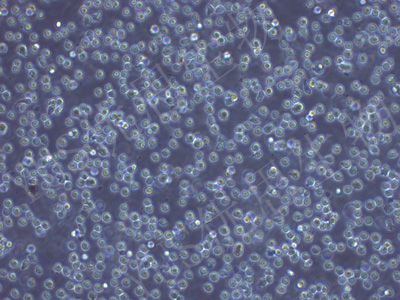

产品中心
产品中心
-

TM3 小鼠睾丸间质细胞(STR鉴定)
货号:YLM001规格: 1*10^6 -

J774A.1 小鼠单核巨噬细胞(STR鉴定)
货号:YLM002规格: 1*10^6 -

4T1 小鼠乳腺癌细胞(STR鉴定)
货号:YLM003规格: 1*10^6 -

MB-49 小鼠膀胱癌细胞(种属鉴定)
货号:YLM004规格: 1*10^6 -
OKT11 小鼠杂交瘤(抗CD2)细胞(种属鉴定)
货号:YLM006规格: 1*10^6 -

L5178Y TK+/- clone(3.7.2C) 小鼠淋巴瘤细胞(STR鉴定)
货号:YLM007规格: 1*10^6 -

OKT3 小鼠杂交瘤细胞(抗CD3)(STR鉴定)
货号:YLM008规格: 1*10^6 -

LWnt-3A 小鼠皮下结缔组织细胞(种属鉴定)
货号:YLM009规格: 1*10^6 -

OP9 小鼠骨髓基质细胞(STR鉴定)
货号:YLM010规格: 1*10^6 -

Beta-TC-6 小鼠胰岛素瘤胰岛β细胞(STR鉴定)
货号:YLM011规格: 1*10^6 -

HT22 小鼠海马神经元细胞(STR鉴定)
货号:YLM012规格: 1*10^6 -

Ana-1 小鼠巨噬细胞(种属鉴定)
货号:YLM013规格: 1*10^6
在线咨询
Online consultation

关注微信公众号


